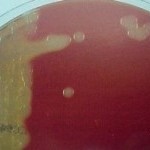
Figura 1 - Cultivo em ágar sangue
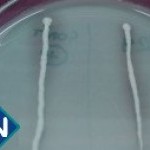
Figura 6 - DNAse

Caso nº 11
Caso Clínico #13
Local: Curitiba-PR
Mês / Ano: Agosto/2001
Assuntos relacionados: MENINGITE. SEPSIS NEONATAL. SEXO FEMININO.
Quadro Clínico
Paciente do sexo feminino com 36 horas de vida, nascido após 27 semanas de gestação, pesando 1.200 g, apresentou fontanela abaulada, freqüências respiratória e cardíaca aumentadas e flutuações pronunciadas na pressão arterial.
Foi requisitado um hemograma e um exame de líquor completo com bacterioscopia e cultura. Após 24 horas da coleta do líquor foi requisitado um 2º hemograma.
Com base nos dados clínicos e laboratoriais, propomos as seguintes questões para discussão do caso:
1 - Qual o provável diagnóstico deste paciente, considerando-se os dados clínicos?
2 - Por que os níveis de proteína no LCR geralmente estão aumentados em situações como esta?
3 - A que se deve a diminuição do nível de glicose em relação ao LCR normal?
4 - Que tipos de pacientes são os mais predispostos a este tipo de infecção?
5 - Qual a faixa etária em que estas infecções são prevalentes?
6 - Quais microrganismos são mais freqüentes em meningites neonatais?
7 - Qual o provável agente etiológico da infecção neste caso clínico? Qual a antiga denominação deste micro-organismo?
8 - Por que é importante identificar precisamente o microrganismo causador de meningite neonatal?
9 - Por que foi realizada a prova de indol neste caso, e por que não se usou o reativo de Kovacs para a revelação?
10 - Quais antibióticos poderiam ser utilizados no tratamento desta infecção?
11 - Que resultado de hemograma seria esperado de um prematuro em boas condições de saúde, com coleta realizada a partir de sangue de cordão?
12 - Que resultado de hemograma seria esperado de um prematuro em boas condições de saúde, com coleta realizada a partir de punção venosa, 24 horas após o nascimento?
13 - Um prematuro em boas condições de saúde, na sua evolução, faraá anemia? Em caso positivo, que tipo de anemia ele fará?
14 - Que explicação se dá para o hemograma coletado no mesmo momento da coleta do LCR e o hemograma coletado 24 horas após?
Referências Bibliográficas
1. SILVA, P. H. & HASHIMOTO, Y. Interpretação Laboratorial do Eritrograma. São Paulo, Ed. Lovise, 1999.
2. PILONETTO, M. & PILONETTO, D.V. Manual de procedimentos laboratoriais em Microbiologia. Curitiba, Ed. Microscience, 1998.
3. UNIVERSIDADE FEDERAL DO PARANÁ. Manual do Laboratório. Curitiba, Hospital de Clínicas, 1990.
4. ALBINI, C. A.; SOUZA, D. C. & SOUZA, H. A. P. H . M. Diagnóstico Laboratorial dos Bacilos Gram Negativos Facultativos Não Fermentadores da Glicose. Curitiba, Newprov Produtos para Laboratório, 2001.
5. MAZA, L. M ; PEZZLO, M. T. & BARON, E. J. Color Atlas of Diagnostic Microbiology. St. Louis, Mosby, 1997.
6. MAHON, C.R. & MANUSELIS Jr., G. Textbook of Diagnostic Microbiology. Philadelphia, W.B. Saunders Company, 1995.
7. KONEMAN, E.W. et al. Color Atlas and Textbook of Diagnostic Microbiology. 5th Ed. Philadelphia, Lippincott, 1997.
8. MURRAY, P.R. Manual of Clinical Microbiology. 7th Ed. Washington, ASM Press, 1999.
9. OPLUSTIL, C.P.; ZOCCOLI, C.M.; TOBOUTI, N.R.; SINTO, S.I. Procedimentos Básicos em Microbiologia Clínica. São Paulo, Sarvier, 2000.
10. SCHAETER, M.; MEDOFF, G.; EISENSTEIN, B.I.; GUERRA, H. Microbiologia: Mecanismos de las Enfermedades Infecciosas. 2da. Ed. Editorial Medica Panamericana, Madrid, 1994.
Dados Laboratoriais
|
1º Hemograma: coletado no momento da coleta do LCR |
|
Eritrócitos 3.900.000 / mL Leucócitos 6.300 / mL Plaquetas 231.000 / mL |
O líquor desta criança que apresentou-se turvo, com 3.800 leucócitos/mL (90% de neutrófilos), glicose 5 mg/dL e proteína 300 mg/dL.
A coloração de Gram do LCR apresentou bacilos gram negativos finos, e no cultivo em ágar sangue desenvolveram-se colônias com o aspecto mostrado na figura 1.
|
2º Hemograma: coletado 24 horas após a coleta do LCR |
|
Eritrócitos 3.640.000 / mL Leucócitos 2.300 / mL Plaquetas 330.000 / mL Granulações tóxicas ++ |
A oxidase das colônias foi positiva, e quando repicadas para ágar Mac Conkey, estas colônias não se desenvolveram. Os testes de motilidade e urease foram negativos, e a produção de indol mostrou-se fraca após revelação com reativo de Ehrlich.
Foram realizadas também as provas de OF-Glicose (Figura 2), nitrato (Figura 3), bile esculina (Figura 4), gelatina (Figura 5) e DNAse (Figura 6).
Respostas da discussão
1 - Os sinais clínicos são sugestivos de meningite e sepsis neonatal.
2 - Os níveis de proteína estão aumentados devido à inflamação.
3 - A diminuição do nível de glicose se deve, em parte, ao metabolismo dos leucócitos, e por outra parte ao metabolismo bacteriano.
4 - A meningite bacteriana é mais comum nos pacientes muito jovens, nos muito idosos e nos imunocomprometidos.
5 - A meningite bacteriana é prevalente em crianças de 2 meses a 5 anos de idade.
6 - A causa mais comum de meningite neonatal é a infecção causada por estreptococos do grupo B (Streptococcus agalactiae), na faixa etária de 0 a 2 meses. Outras bactérias envolvidas são a Listeria monocytogenes e membros da família Enterobacteriaceae, dentre eles a Escherichia coli, a Klebsiella pneumoniae e o Citrobacter diversus.
7 - Com base na morfologia celular e colonial e nas características bioquímicas, a bactéria provável é Cryseobacterium meningosepticum, denominação antiga: Flavobacterium meningosepticum.
8 - Porque algumas bactérias, como o Cryseobacterium meningosepticum, podem provocar o surgimento de epidemias em enfermarias de neonatos, com altas taxas de mortalidade (até 55%).
9 - A prova de indol é importante na identificação de bacilos gam negativos não fermentadores da família Flavobacteriaceae, que podem ser suspeitados pela coloração amarelada das colônias oxidase positivas desenvolvidas em ágar sangue. Foi utilizado o reativo de Ehrlich ao invés do reativo de Kovacs para a revelação da prova por ser o primeiro mais sensível, já que a quantidade de indol produzida por estas bactérias pode ser pequena.
10 - Antibióticos usados para tratar infecções por bactérias gram positivas, como rifampicina, clindamicina, eritromicina, esparfloxacina, sulfametoxazol-trimetoprim e vancomicina. Cryseobacterium spp. apresentam resistência intrínseca a muitos antimicrobianos comumente usados para tratar infecções causadas por bactérias gram negativas (aminoglicosídeos, beta-lactâmicos, tetraciclinas e cloranfenicol). Di Pentima e cols. (1998) encontraram evidências clínicas de que a combinação de vancomicina e rifampicina intravenosas é um esquema adequado para o tratamento empírico inicial da meningite por C. meningosepticum em recém-natos.
11 - A coleta a partir de sangue de cordão, em prematuro em boas condições de saúde, apresenta um valor de hemoglobina em torno de 18,0 g/dL. A leucocitose é variável mas sempre está presente. Esta leucocitose se dá as custas de neutrofilia.
12 - A hemoglobina fica em um valor variando entre 12 a 15,0 g/dL. A leucocitose permanece as custas de neutrofilia.
13 - O prematuro tende a fazer uma anemia ferropriva porque ele não tem reserva de ferro. Durante sua evolução ele deve ser suplementado com ferro.
14 - No momento da coleta o hemograma não apresenta alteração leucocitária porque a migração dos leucócitos se volta toda para o LCR. O segundo hemograma mostra uma leucopenia com intenso desvio nuclear à esquerda, com presença de granulações tóxicas e corpúsculos de Döhle. Este quadro hematológico fala a favor de um processo infeccioso grave, bacteriano e causado por bactéria gram negativa, devido a leucopenia. Se não for bactéria gram negativa, o quadro hematológico fala a favor de processo bacteriano grave com exaustão de medula óssea.